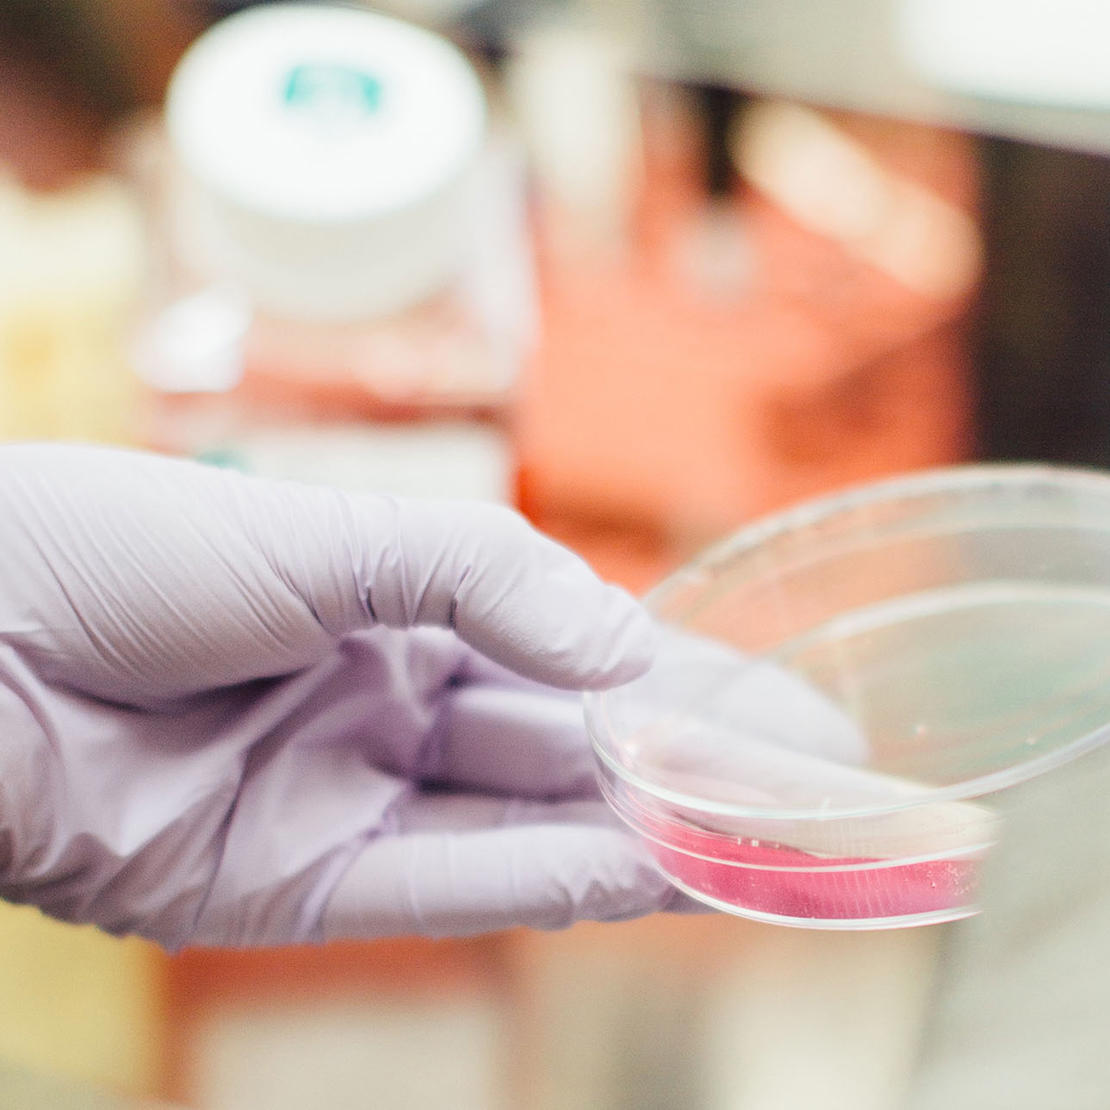

Brug os
Brug Cystisk Fibrose Foreningen. Vi har nemlig en lang række tilbud til dig.

Har du brug for materialer om cystisk fibrose? Vi har samlet alle vores materialer her.
Vi har gjort det let for dig, og samlet alle vores pjecer og informationsmaterialer om cystisk fibrose her. Du er velkommen til at kontakte os, hvis der er informationer du mangler.

Se alle pjecer og bøger fra Cystisk Fibrose Foreningen.

Barnets bog om cystisk fibrose er en bog, som forældre kan lave sammen med deres barn, som har cystisk fibrose. Bogen støtter barnet i dets kommunikation om cystisk fibrose og kan bruges som udgangspunkt for snak med både voksne og kammerater om det at have cystisk fibrose.

Se videoer om cystisk fibrose, hvor Erik Wendel, der selv har cystisk fibrose, fortæller om sygdommen fra top til tå.

Se videoer, hvor personer med cystisk fibrose og pårørende fortæller, hvordan det er at leve med sygdommen.
Se forskellige videopræsentationer af dansk forskning og behandling af cystisk fibrose.

I disse podcasts kan du høre gribende fortællinger fra personer, der lever med cystisk fibrose og fra pårørende til personer med cystisk fibrose.

I bogen De Kronisk Syge, bringer Ungdomsbureauet en række personlige beretninger fra unge der lever med en kronisk sygdom. En af dem er Maja på 15 år, som har cystisk fibrose og du kan læse hendes historie via linket her på siden.

Brug Cystisk Fibrose Foreningen. Vi har nemlig en lang række tilbud til dig.
Du kan støtte Cystisk Fibrose Foreningen på flere måder:

Forskning er nøglen til ny og bedre behandling for børn, unge og voksne med cystisk fibrose.